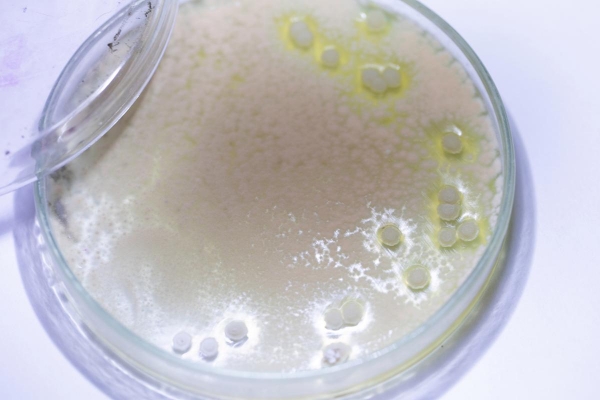

干木耳泡发,炒一炒,清脆爽口,很多人都爱。但就是这么一道看起来再普通不过的食材,如果泡错了方式,真的能致命。不是吓唬人,是真的有病例。

不少人看到"木耳毒死7人"这样的标题第一反应是:又在制造恐慌吧?但仔细看看,是泡发方式出了问题。不是说木耳本身有毒,而是它在不当保存的过程中,会"变脸"。
很多人会把木耳泡上一晚上,甚至泡两天,想着泡得越软越好,结果就给了细菌滋生的时间。这时候产生的不是普通细菌,而是致命的--椰毒假单胞菌。
这个名字陌生?没关系,但它造成的后果你一定无法忽视。它产生的毒素叫"米酵菌酸",是一种稳定性极强的毒素,高温也杀不掉,煮沸也没用。
不是所有发霉、变味的食物都能引起中毒,但米酵菌酸不同。它生在你看不出来的地方,没味道、没颜色、没气味,吃进肚子才知道出事了。而且,它的发作速度快、致死率高,一点都不像"食物中毒"那么简单。
有研究指出,米酵菌酸的致死剂量极低,0.1毫克/kg就可能致人死亡。跟砒霜比起来,它的毒性一点也不逊色。砒霜至少还有苦味、刺激味,而这种毒素,悄无声息就进了体内。
中毒后最先出问题的是肝和脑。开始可能就是恶心、呕吐、腹胀,很多人觉得是普通胃肠炎,拖着不去看医生。但接下来可能出现意识模糊、昏迷,甚至肝功能衰竭,等发现严重了,往往已经来不及。
更麻烦的是,目前还没有特效解毒药。治疗只能靠支持疗法,也就是靠身体自己扛。一旦中毒,能不能活下来,完全看个人体质和运气,这就让医生也很被动。

不少人会说:我泡了一辈子木耳都没事啊。没错,确实绝大多数人都不会因此中毒。但这不是说明安全,而是说明你运气好。一旦遇上致病菌繁殖,风险就是100%。
而这种菌喜欢的环境就是--温暖、潮湿、富含有机物。简单来说,夏天、室温泡发、时间超过八小时,就是给它大开绿灯。
很多人为了省事,用冷水泡着木耳放在厨房一角,第二天早上再炒,这种做法就是典型的"自埋雷"。湿度、温度、时间都满足了致病菌的"成长需求"。
甚至有些人泡完后,木耳有点黏,闻着也没啥味道,就照样吃下去。黏滑感正是细菌繁殖的结果,但它不一定有异味,别相信"闻起来没事就能吃"。

市面上曾有过因为泡发木耳而群体中毒的事件,死亡率高达50%以上。这不是耸人听闻,而是医学期刊里白纸黑字的记录。
除了木耳,类似的风险还存在于腐竹、银耳、粉条、海带这些干货里。只要是长时间泡发、低温保存不当,都可能成为米酵菌酸的温床。
这里要特别提一句:冷藏≠安全。很多人以为泡发后放冰箱就没事了,但米酵菌酸的产生不是靠高温,而是时间。即使在低温环境下,时间一长,也可能出问题。
那泡木耳到底该怎么做才安全?其实一点都不复杂。第一,泡发时间不超过四小时,尤其夏天。第二,用凉白开或者净水,不要用自来水直接泡。第三,泡完立刻做,别再"放一放"。

还有人喜欢一次泡一大盆,吃几天,这种做法绝对不可取。当天泡、当天吃,是底线。别省这点小事,命重要。
如果你看到泡发后的木耳发粘、有气泡、颜色暗沉,那就扔掉,别心疼。一个菜的钱,换一条命,不值得。
有些人可能会问:那干木耳是不是就安全?干的当然没问题,但只要你泡了,就要注意保存方式。泡发是转折点,前后两个世界。
还有一个隐藏的风险是"重复泡发"。有家庭主妇泡了一锅木耳,吃了一半,剩下的继续加水泡着等第二天再吃,这种做法极其危险。泡过一次的木耳,环境已经被细菌污染,再泡就是"孵菌"。

如果你实在喜欢提前准备,那就泡完之后尽快焯水、炒熟,然后放进冰箱冷藏保存,不超过24小时。熟制后的食品比生的更安全,但也不是万能,时间依然是关键。
这不是"谈菌色变",也不是"食品焦虑"。而是提醒你:每种食材都有它的脾气,木耳的脾气就是--泡久了,就翻脸。
一个看似健康的食材,一旦处理不当,反而成了健康的反面教材。越是"绿色天然"的东西,越不能掉以轻心。
我们总说"病从口入",但其实很多时候,并不是吃错了什么,而是吃对的东西,错了方式。
木耳是一种营养丰富的好食材,富含多糖、铁、钙,但要发挥它的好处,前提是你得给它一个干净、安全的"入肚之路"。

别再迷信"泡得越久越软越好"这种经验了。经验不等于科学,尤其是跟健康有关的事。用科学的方式对待食物,是我们每个人该有的底线。
最后提醒一点,如果吃完某种泡发食材后出现持续性腹泻、呕吐、腹胀,尤其是伴随意识模糊,立刻就医。别想着"扛一扛就过去",那可能是身体在发出最后的求救信号。
食材是死的,但方式是活的。你怎么处理它,它就怎么回馈你。泡发木耳这件事,不是小事,它可以是你餐桌上的营养品,也可以是一场灾难的入口。










